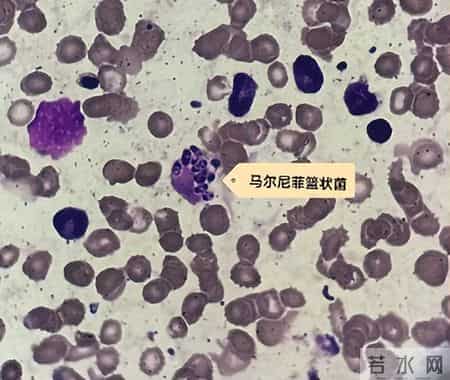
男子为滋补身体吃了它，突然高烧近40℃，肺都“烂穿”！医生：有极大风险……

好好的人
突然高烧到快40℃
浑身疼得像是被揍了一顿
去医院做CT一查
肺都“烂了”
什么病这么猛?
近日,浙江大学医学院附属第一医院呼吸内科接诊了一位40岁的男子壮哥(化名),其称自己一向身强力壮,前段时间突然高烧,全身骨头缝都疼,硬抗一周后前来就诊。
壮哥经检查:胸部CT双肺弥漫性病灶,血氧饱和度指标不到70%。“重症肺炎,I型呼吸衰竭。再拖下去有生命危险!”他随即被安排住院治疗,并做了基因检测,揪出了真凶——马尔尼菲篮状菌。

壮哥的肺部情况
“您近期饲养或宰杀过什么动物吗?去过山林或潮湿的地方吗?”追问之下才知道,身手矫健的壮哥经常到山区竹林里抓竹鼠吃。他觉得竹鼠是滋补好物,吃肉能补身体,冬天来一碗竹鼠汤更是浑身都暖和。
经过抗真菌等一系列治疗后,壮哥的呼吸衰竭症状明显改善,胸部CT复查也显示病灶明显吸收好转。如今,他已经临床治愈,带药出院回家进行巩固治疗。
带菌率达96%
吃、抓、养都有感染风险
造成真菌感染的马尔尼菲篮状菌,原名“马尔尼菲青霉菌”,其一旦钻进人体,会引起致死性深部真菌感染,人和竹鼠是其仅有的宿主。
东南亚地区及我国南方,如广西、广东、云南等地温暖潮湿,适合竹林和甘蔗生长,常有竹鼠出没。其中银星竹鼠的带菌率高达96%。
除了吃竹鼠,直接接触竹鼠、吸入竹鼠洞内粉尘或间接接触被竹鼠粪便等污染的环境都可能导致感染。
医生强调,接触过竹鼠的人:不管是抓过、养过还是吃过,都有极大的感染风险。同时,在竹鼠活跃的区域,饮水饮食必须充分加热煮熟,以避免食用带有马尔尼菲篮状菌的食物和水。
此外需要提醒,野生竹鼠是国家保护动物,禁止食用和非法捕猎。
声明
本文来源于广州日报、FM93交通之声、浙大一院。以上图文,贵在分享,版权归原作者及原出处所有,内容仅为作者观点,并不代表本公众号立场。如涉及版权等问题,请及时与我们联系。
本站是社保查询公益性网站链接,数据来自各地人力资源和社会保障局,具体内容以官网为准。
定期更新查询链接数据 苏ICP备17010502号-11